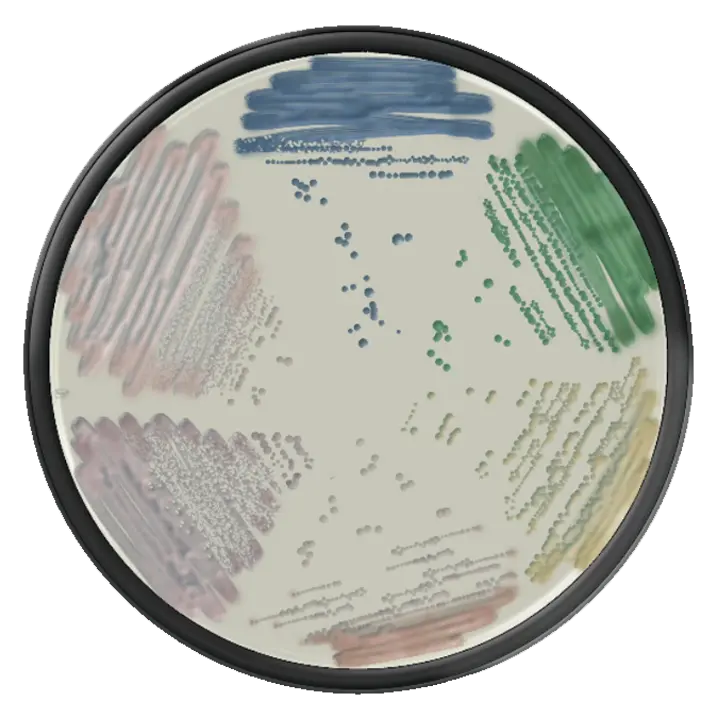

Micosis superficiales
Mayra Alejandra Ortiz Pérez
con importancia clínica
Ingrid Odaliz Pérez Chica
Micosis superficiales con importancia clínica
Mayra Alejandra Ortiz Pérez
Ingrid Odaliz Pérez Chica
Micosis superficiales con importancia clínica
Mayra Alejandra Pérez Ortiz
Ingrid Odaliz Pérez Chica
Métodos diagnósticos comúnes, identificación macro y microscópica de Dermatofitos y Levaduras
índice
04 Dermatofitos (Especie -Epidermophyton)
05 Levaduras (Especie - Cándida)

Las micosis superficiales constituyen un grupo de infecciones frecuentes que afectan principalmente a la piel, pelo y uñas, y cuya importancia clínica radica tanto en su elevada prevalencia como en su impacto estético, social y, en algunos casos, funcional. Estas infecciones son producidas por un conjunto diverso de hongos, dentro de los cuales destacan los dermatofitos y ciertas levaduras, organismos capaces de colonizar estructuras queratinizadas del cuerpo humano. Su comportamiento biológico, manifestaciones clínicas y métodos diagnósticos presentan características particulares que requieren una comprensión precisa para su adecuado abordaje...
Las micosis superficiales constituyen un grupo de infecciones frecuentes que afectan principalmente a la piel, pelo y uñas, y cuya importancia clínica radica tanto en su elevada prevalencia como en su impacto estético, social y, en algunos casos, funcional. Estas infecciones son producidas por un conjunto diverso de hongos, dentro de los cuales destacan los dermatofitos y ciertas levaduras, organismos capaces de colonizar estructuras queratinizadas del cuerpo humano. Su comportamiento biológico, manifestaciones clínicas y métodos diagnósticos presentan características particulares que requieren una comprensión precisa para su adecuado abordaje...